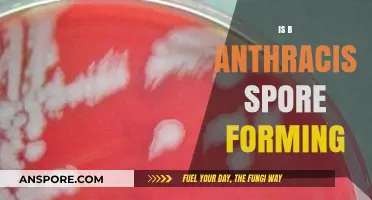
Understanding B. Anthracis: The Science Behind Its Spore-Forming Abilities

Breathing mold spores can pose significant health risks, particularly for individuals with allergies, asthma, or compromised immune systems. Mold spores are microscopic particles released by fungi as part of their reproductive process, and when inhaled, they can trigger allergic reactions, respiratory issues, and other symptoms such as coughing, sneezing, and skin irritation. Prolonged exposure to certain types of mold, like black mold (Stachybotrys chartarum), may lead to more severe health problems, including fungal infections or toxic reactions. Vulnerable populations, including children, the elderly, and those with pre-existing health conditions, are especially at risk. While occasional exposure to low levels of mold spores is generally harmless for most people, persistent or high concentrations in indoor environments can be dangerous, underscoring the importance of addressing mold growth promptly to safeguard health.
| Characteristics | Values |
|---|---|
| Health Risks | Breathing mold spores can cause allergic reactions, respiratory issues, asthma attacks, and infections, especially in immunocompromised individuals. |
| Symptoms | Common symptoms include sneezing, coughing, wheezing, nasal congestion, skin irritation, throat irritation, and eye irritation. |
| Vulnerable Populations | Children, the elderly, pregnant women, and people with pre-existing respiratory conditions (e.g., asthma) or weakened immune systems are at higher risk. |
| Toxic Molds | Certain molds, like Stachybotrys chartarum (black mold), produce mycotoxins that can cause severe health issues when inhaled over time. |
| Short-Term Exposure | Generally less harmful but can still trigger allergic reactions or mild respiratory symptoms in sensitive individuals. |
| Long-Term Exposure | Prolonged exposure increases the risk of chronic respiratory conditions, lung infections, and systemic health problems. |
| Indoor vs. Outdoor Mold | Indoor mold exposure is more dangerous due to higher concentrations in enclosed spaces, while outdoor mold spores are typically less concentrated and less harmful. |
| Prevention Measures | Reduce humidity levels, fix leaks, improve ventilation, clean moldy surfaces promptly, and use air purifiers with HEPA filters. |
| Medical Advice | Consult a healthcare professional if symptoms persist or worsen after mold exposure, especially for vulnerable populations. |
| Latest Research (as of 2023) | Studies emphasize the link between mold exposure and increased risk of respiratory diseases, highlighting the importance of early detection and remediation. |
| Environmental Factors | Mold thrives in damp, humid environments (e.g., bathrooms, basements) and on organic materials like wood, paper, and fabric. |
| Occupational Hazards | Workers in water-damaged buildings, construction, or agriculture are at higher risk of mold exposure and related health issues. |
| Testing and Remediation | Professional mold testing and remediation are recommended for severe infestations to ensure complete removal and prevent recurrence. |
| Global Health Impact | Mold exposure is a significant public health concern, contributing to millions of cases of respiratory illnesses worldwide annually. |
What You'll Learn

Short-term exposure effects
Breathing mold spores, even briefly, can trigger immediate reactions in sensitive individuals. Short-term exposure often manifests as allergic responses, including sneezing, runny or stuffy nose, and itchy or watery eyes. These symptoms resemble seasonal allergies but are directly linked to mold presence. For instance, spending a few hours in a damp basement or mold-infested room might cause someone with mold sensitivity to experience these effects within minutes to hours. The severity depends on the concentration of spores inhaled and the individual’s immune response.
Children, the elderly, and those with pre-existing respiratory conditions are particularly vulnerable. Short-term exposure can exacerbate asthma symptoms, leading to coughing, wheezing, or shortness of breath. A study by the EPA highlights that even low to moderate levels of mold spores can provoke asthma attacks in susceptible individuals. For example, a child playing in a moldy playroom might develop wheezing within 30 minutes to an hour. Practical precautions include using air purifiers with HEPA filters and ensuring proper ventilation in enclosed spaces.
Comparatively, healthy adults may experience milder effects, such as throat irritation or skin rashes, after brief exposure. However, the risk escalates in environments with high mold concentrations, like water-damaged buildings. A dosage analogy can be drawn here: inhaling a small number of spores might cause minor discomfort, while prolonged exposure to dense spore clouds can lead to more severe reactions. To mitigate risks, avoid areas with visible mold growth and wear masks when cleaning moldy surfaces.
Persuasively, it’s crucial to recognize that short-term exposure effects are not always immediate. Some individuals may develop symptoms up to 24 hours after exposure, making it harder to pinpoint mold as the culprit. Keeping a symptom journal can help identify patterns. For instance, if nasal congestion or headaches occur consistently after visiting a specific location, mold could be the hidden trigger. Early detection and avoidance are key to preventing repeated exposure and potential long-term health issues.
Mastering Spore: Crafting Your Own Unique Planet Step-by-Step
You may want to see also

Long-term health risks
Breathing mold spores over extended periods can lead to chronic respiratory conditions, particularly in individuals with pre-existing sensitivities or weakened immune systems. Prolonged exposure to common indoor molds like *Aspergillus*, *Penicillium*, and *Stachybotrys* (black mold) has been linked to persistent inflammation of the airways, a condition often misdiagnosed as asthma or chronic bronchitis. For instance, a study published in the *Journal of Allergy and Clinical Immunology* found that individuals living in mold-infested homes were 30-50% more likely to develop chronic coughs and wheezing, even after controlling for other allergens. This underscores the importance of identifying and mitigating mold sources in living environments, especially in damp areas like basements, bathrooms, and kitchens.
Children and the elderly are particularly vulnerable to the long-term health risks of mold exposure. In children, prolonged inhalation of mold spores can impair lung development, leading to reduced lung function that persists into adulthood. A longitudinal study from the *American Journal of Respiratory and Critical Care Medicine* revealed that children exposed to mold during their first year of life had a 20% higher risk of developing asthma by age 7. For the elderly, whose immune systems are naturally compromised, mold exposure can exacerbate existing conditions like COPD or pneumonia, increasing the likelihood of hospitalization. Practical steps to protect these groups include using dehumidifiers to maintain indoor humidity below 50%, regularly cleaning air vents, and promptly fixing leaks to prevent mold growth.
One of the most insidious long-term risks of mold exposure is its potential to cause systemic inflammation, which can contribute to cardiovascular problems. Mold spores and their byproducts (mycotoxins) can enter the bloodstream, triggering an immune response that leads to chronic inflammation throughout the body. Over time, this inflammation can damage blood vessels and increase the risk of hypertension, heart attacks, and strokes. A study in *Environmental Health Perspectives* found that individuals with prolonged mold exposure had a 15% higher incidence of cardiovascular disease compared to those living in mold-free environments. To mitigate this risk, it’s crucial to conduct regular mold inspections, especially in older homes or buildings with water damage, and to use HEPA air filters to reduce spore circulation.
Finally, the psychological toll of long-term mold exposure should not be overlooked. Chronic exposure to mold has been associated with cognitive impairments, mood disorders, and reduced quality of life. Mycotoxins can cross the blood-brain barrier, potentially causing symptoms like memory loss, anxiety, and depression. A study in *Applied and Environmental Microbiology* highlighted that individuals living in moldy environments scored significantly lower on cognitive tests and reported higher levels of fatigue and irritability. Addressing this risk requires a holistic approach: not only removing mold but also improving indoor air quality through proper ventilation and, in severe cases, professional mold remediation. Early intervention is key to preventing these long-term neurological and psychological effects.
Mastering Spore: Strategies to Recruit an Epic Team Member
You may want to see also

Vulnerable populations risks
Breathing mold spores poses heightened risks for vulnerable populations, whose immune systems or respiratory health may be compromised. Infants, children under five, and the elderly are particularly susceptible due to underdeveloped or weakened immune responses. For example, prolonged exposure to mold spores in damp environments can exacerbate respiratory conditions like asthma in children, leading to frequent attacks and long-term lung damage. Similarly, older adults often experience reduced lung capacity and chronic illnesses, making them more prone to infections from mold-related pathogens.
Consider the case of individuals with pre-existing respiratory conditions, such as chronic obstructive pulmonary disease (COPD) or cystic fibrosis. Mold spores act as irritants, triggering inflammation and mucus production, which can severely impair breathing. A study by the World Health Organization found that patients with COPD exposed to mold had a 30% higher risk of hospitalization compared to those in mold-free environments. Practical steps for this group include using HEPA air filters, maintaining indoor humidity below 50%, and avoiding areas with visible mold growth, such as basements or bathrooms with poor ventilation.
Immunocompromised individuals, including those undergoing chemotherapy, living with HIV/AIDS, or taking immunosuppressive medications, face unique dangers. Mold spores can lead to opportunistic infections like aspergillosis, a fungal infection with a mortality rate exceeding 50% in severe cases. For instance, *Aspergillus* spores, commonly found in water-damaged buildings, can colonize the lungs of these individuals, causing fever, chest pain, and coughing up blood. To mitigate risks, immunocompromised people should avoid moldy areas, wear N95 masks during cleanup, and ensure caregivers follow strict hygiene protocols.
Pregnant women and their unborn children are another at-risk group. Mold exposure during pregnancy has been linked to preterm birth and low birth weight, as spores can trigger systemic inflammation affecting fetal development. A 2018 study published in *Environmental Health Perspectives* found that women exposed to mold in the home were 2.5 times more likely to experience pregnancy complications. Expectant mothers should prioritize mold inspections, promptly address leaks, and use dehumidifiers in moisture-prone areas like kitchens and laundry rooms.
Finally, low-income households often face disproportionate risks due to substandard housing conditions, such as leaky roofs, inadequate insulation, and poor ventilation. These environments foster mold growth, exposing residents to chronic spore inhalation. A 2020 CDC report highlighted that children in low-income housing were twice as likely to develop mold-related asthma. Advocacy for affordable housing improvements, community education on mold prevention, and access to remediation resources are critical steps to protect these populations.
In summary, vulnerable populations face amplified health risks from mold spores, requiring targeted interventions. From infants to the immunocompromised, understanding these risks and implementing practical measures can significantly reduce adverse outcomes. Awareness, prevention, and proactive management are key to safeguarding these groups from the dangers of mold exposure.
Understanding Coccidioidomycosis: How Long Do Its Spores Survive in Soil?
You may want to see also

Common mold types dangers
Breathing mold spores can pose significant health risks, but the severity depends largely on the type of mold and the individual’s sensitivity. Common indoor molds like *Cladosporium*, *Penicillium*, and *Aspergillus* are widespread and often harmless in small amounts. However, prolonged exposure or high concentrations can trigger allergic reactions, respiratory issues, and, in rare cases, severe infections. Understanding the dangers of specific mold types is crucial for mitigating health risks effectively.
Consider *Stachybotrys chartarum*, often referred to as "black mold," which thrives in damp, water-damaged environments. This mold produces mycotoxins that, when inhaled, can cause chronic coughing, nasal congestion, and even memory loss in severe cases. While not all black molds produce toxins, their presence warrants immediate remediation. For households with children or immunocompromised individuals, reducing exposure is critical. Practical steps include fixing leaks promptly, maintaining indoor humidity below 60%, and using air purifiers with HEPA filters to capture airborne spores.
In contrast, *Aspergillus* is a common mold found both indoors and outdoors, with over 180 species. While most are harmless, certain strains like *Aspergillus fumigatus* can cause aspergillosis, a fungal infection particularly dangerous for those with weakened immune systems. Inhaling large quantities of its spores can lead to allergic reactions or, in severe cases, invasive aspergillosis, which has a mortality rate of up to 90% in immunocompromised patients. Hospitals and healthcare facilities must monitor indoor air quality rigorously to protect vulnerable populations.
Another prevalent mold, *Penicillium*, is often found on water-damaged materials and food. While some species are used in antibiotic production, others release mycotoxins that can irritate the respiratory system and exacerbate asthma. Prolonged exposure may lead to chronic bronchitis or other respiratory conditions. To minimize risk, inspect stored food regularly, discard moldy items immediately, and ensure proper ventilation in kitchens and bathrooms.
Comparatively, *Cladosporium* is less toxic but more allergenic, commonly found on fabrics, wood, and damp window sills. Its spores are ubiquitous outdoors and can easily enter homes through open windows or HVAC systems. For allergy sufferers, exposure can cause sneezing, itchy eyes, and skin rashes. Reducing indoor spore counts involves regular cleaning with mold-inhibiting solutions and limiting outdoor air intake during high-spore seasons, typically late summer and fall.
In summary, the dangers of breathing mold spores vary by type, with some causing mild allergies and others leading to severe infections. Identifying the specific mold present and taking targeted preventive measures can significantly reduce health risks. Whether through professional remediation, improved ventilation, or vigilant cleaning, addressing mold proactively is essential for maintaining a healthy indoor environment.
Apogamous Plants: Unveiling the Unique Process of Spores Production
You may want to see also

Preventing mold exposure tips
Breathing mold spores can trigger allergic reactions, asthma attacks, and respiratory issues, especially in sensitive individuals like children, the elderly, and those with compromised immune systems. Preventing mold exposure is crucial for maintaining indoor air quality and safeguarding health. Here’s how to minimize risks effectively.
Control Indoor Humidity Levels
Mold thrives in damp environments, so maintaining humidity below 60% is essential. Use dehumidifiers in basements, bathrooms, and other moisture-prone areas. Regularly check humidity levels with a hygrometer, available for under $20 at most hardware stores. Fix leaks promptly, as even small drips can create ideal conditions for mold growth within 24–48 hours. Ensure proper ventilation by using exhaust fans during showers and while cooking.
Inspect and Clean Regularly
Mold often hides in inconspicuous places like behind walls, under sinks, and inside air conditioning units. Conduct quarterly inspections, focusing on areas with past water damage or persistent dampness. Clean visible mold with a solution of one cup bleach per gallon of water, wearing gloves and a mask to avoid exposure. For larger infestations, consult professionals to prevent spore dispersal during removal.
Improve Air Circulation
Stagnant air promotes mold growth by allowing moisture to settle on surfaces. Open windows when weather permits, and use fans to enhance airflow. In colder months, ensure furniture is at least 2–3 inches away from exterior walls to prevent condensation. Consider investing in an air purifier with a HEPA filter, which captures mold spores and other airborne particles, reducing indoor allergens.
Choose Mold-Resistant Materials
When renovating or building, opt for mold-resistant products like moisture-resistant drywall, paint, and insulation. These materials are treated with antimicrobial agents that inhibit mold growth. Avoid carpeting in basements or bathrooms, as it traps moisture and provides a breeding ground for mold. Instead, use tile, hardwood, or mold-resistant flooring options.
Educate and Act Proactively
Understanding the early signs of mold—musty odors, water stains, or peeling wallpaper—can prevent small issues from becoming major problems. Educate household members on the importance of drying wet items immediately, such as towels, clothing, and rugs. Store firewood and plants outdoors, as they can harbor mold spores. By staying vigilant and taking preventive measures, you can significantly reduce the risk of mold exposure and its associated health hazards.
How Spores Survive: Nature's Ingenious Environmental Defense Mechanisms
You may want to see also
Frequently asked questions
Breathing mold spores can be dangerous, especially for individuals with allergies, asthma, compromised immune systems, or respiratory conditions. Healthy individuals may experience mild symptoms or none at all, but prolonged exposure can lead to health issues for anyone.
Common symptoms include sneezing, coughing, nasal congestion, throat irritation, eye irritation, skin rashes, and wheezing. In severe cases, it can cause asthma attacks, respiratory infections, or allergic reactions.
To reduce risk, control indoor humidity below 60%, fix leaks promptly, ensure proper ventilation, clean and dry water-damaged areas within 24–48 hours, and regularly inspect for mold growth, especially in damp areas like bathrooms and basements.